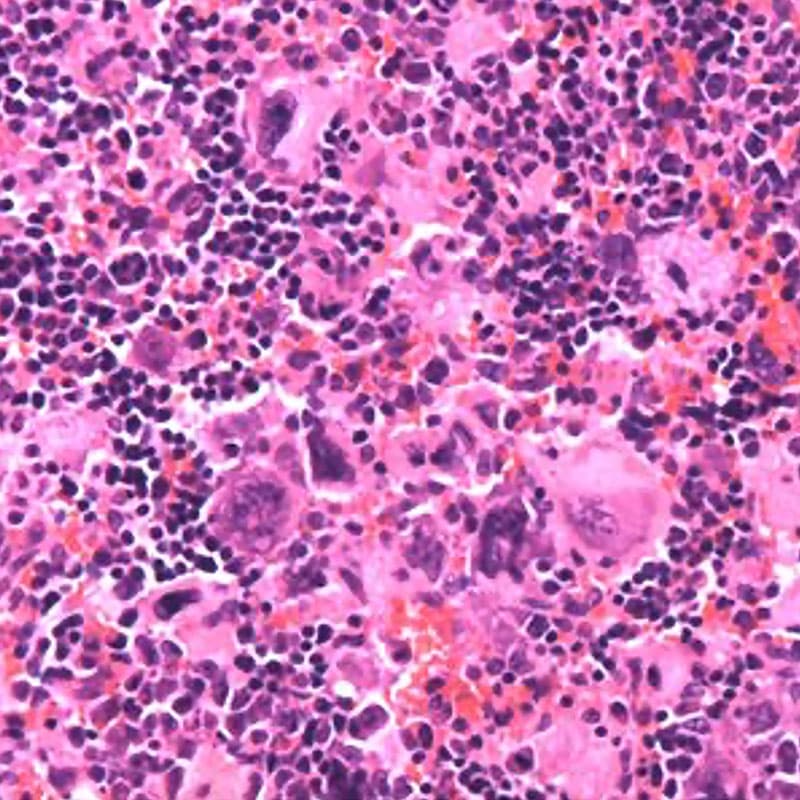
Hematoxylin and eosin staining of Dnm2Plt–/– spleens displaying megakaryocyte hyperplasia.

Selected Original Research Articles
Biswas R,* Boyd EK,* Eaton N, Steenackers A, Schulte ML, Reusswig F, Yu H, Drew C, Kahr WHA, Shi Q, Plomann M, Hoffmeister KM, Falet H. PACSIN2 regulates platelet integrin β1 hemostatic function. J Thromb Haemost. 2023 [Epub ahead of print] (*equal contribution) | PMID: 37678551
Eaton N, Boyd EK, Biswas R, Lee-Sundlov MM, Dlugi TA, Ramsey HE, Zheng S, Burns RT, Sola-Visner MC, Hoffmeister KM, Falet H. Endocytosis of the thrombopoietin receptor Mpl regulates megakaryocyte and erythroid maturation in mice. Front Oncol. 2022;12:959806 | PMID: 36110936
Eaton N, Subramaniam S, Schulte ML, Drew C, Jakab D, Haberichter SL, Weiler H, Falet H. Bleeding diathesis in mice lacking JAK2 in platelets. Blood Adv. 2021;5(15):2969-2981 | PMID: 34342643
Unsworth AJ, Bye AP, Sage T, Gaspar RS, Eaton N, Drew C, Stainer A, Kriek N, Volberding PJ, Hutchinson JL, Riley R, Jones S, Mundell SJ, Cui W, Falet H, Gibbins JM. Anti-platelet properties of Pim kinase inhibition is mediated through disruption of thromboxane A2 receptor signalling. Haematologica. 2021;106(7):1968-1978 | PMID: 32467143
Giannini S, Lee-Sundlov MM, Rivadeneyra L, Di Buduo CA, Burns R, Lau JT, Falet H, Balduini A, Hoffmeister KM. β4GalT1 controls β1 integrin function to govern thrombopoiesis and hematopoietic stem cell homeostasis. Nat Commun. 2020;11:356 | PMID: 31953383
Eaton N, Drew C, Wieser J, Munday AD, Falet H. Dynamin 2 is required for GPVI signaling and platelet hemostatic function in mice. Haematologica. 2020;105(5):1414-1423 | PMID: 31296575
Begonja AJ,* Pluthero FG,* Suphamungmee W, Giannini S, Christensen H, Leung R, Lo R, Nakamura F, Lehman W, Plomann M, Hoffmeister KM, Kahr WHA, Hartwig JH, Falet H. FlnA binding to PACSIN2 F-BAR domain regulates membrane tubulation in megakaryocytes and platelets. Blood. 2015;126(1):80-88 (*equal contribution) | PMID: 25838348
Grozovsky R, Begonja AJ, Liu K, Visner G, Hartwig JH, Falet H,* Hoffmeister KM.* The Ashwell-Morell receptor regulates hepatic thrombopoietin production via JAK2-STAT3 signaling. Nat Med. 2015;21(1):47-54 (*equal contribution) | PMID: 25485912
Bender M,* Giannini S,* Grozovsky R, Jönsson T, Christensen H, Pluthero FG, Ko A, Mullally A, Kahr WHA, Hoffmeister KM, Falet H. Dynamin 2-dependent endocytosis is required for normal megakaryocyte development in mice. Blood. 2015;125(6):1014-1024 (*equal contribution) | PMID: 25468568
Begonja AJ, Hoffmeister KM, Hartwig JH, Falet H. FlnA-null megakaryocytes prematurely release large and fragile platelets that circulate poorly. Blood. 2011;118(8):2285-2295 | PMID: 21652675
Falet H, Pollitt AY, Begonja AJ, Weber SE, Duerschmied D, Wagner DD, Watson SP, Hartwig JH. A novel interaction between FlnA and Syk regulates platelet ITAM-mediated receptor signaling and function. J Exp Med. 2010;107(9):1967-1979 | PMID: 20713593
Falet H, Marchetti MP, Hoffmeister KM, Massaad MJ, Geha RS, Hartwig JH. Platelet-associated IgAs and impaired GPVI responses in platelets lacking WIP. Blood. 2009;114(21):4729-4737 | PMID: 19692704
Falet H, Chang G, Brohard-Bohn B, Rendu F, Hartwig JH. αIIbβ3 signals lead cofilin to accelerate platelet actin dynamics. Am J Physiol Cell Physiol. 2005;289(4):C819-C825 | PMID: 15901596
Hoffmeister KM, Felbinger TW, Falet H, Denis CV, Bergmeier W, Mayadas TN, von Andrian UH, Wagner DD, Stossel TP, Hartwig JH. The clearance mechanism of chilled blood platelets. Cell. 2003;112(1):87-97 | PMID: 12526796
Falet H, Hoffmeister KM, Neujahr R, Italiano JE Jr, Stossel TP, Southwick FS, Hartwig JH. Importance of free actin filament barbed ends for Arp2/3 complex function in platelets and fibroblasts. Proc Natl Acad Sci U S A. 2002;99(26):16782-16787 | PMID: 12464680
Falet H, Hoffmeister KM, Neujahr R, Hartwig JH. Normal Arp2/3 complex activation in platelets lacking WASp. Blood. 2002;100(6):2113-2122 | PMID: 12200375
Falet H, Barkalow KL, Pivniouk VI, Barnes MJ, Geha RS, Hartwig JH. Roles of SLP-76, phosphoinositide 3-kinase, and gelsolin in the platelet shape changes initiated by the collagen receptor GPVI/FcRγ-chain complex. Blood. 2000;96(12):3786-3792 | PMID: 11090061
Selected Review Articles
Falet H, Rivadeneyra L, Hoffmeister KM. Clinical impact of glycans in platelet and megakaryocyte biology. Blood. 2022;139(22):3255-3263 | PMID: 35015813
Li R, Hoffmeister KM, Falet H. Glycans and the platelet life cycle. Platelets. 2016;27(6):505-511 | PMID: 27135356
Hoffmeister KM, Falet H. Platelet clearance by the hepatic Ashwell-Morrell receptor: mechanisms and biological significance. Thromb Res. 2016;141(S2):S68-S72 | PMID: 27207430
Grozovsky R, Giannini S, Falet H, Hoffmeister KM. Regulating billions of blood platelets: glycans and beyond. Blood. 2015;126(16):1877-1884 | PMID: 26330242
Falet H. New insights into the versatile roles of platelet FlnA. Platelets. 2013;24(1):1-5 | PMID: 22372530
Selected Book Chapters
Giannini S, Falet H, Hoffmeister KM. Platelet glycobiology and the control of platelet function and lifespan. In: Platelets. Michelson AD, Cattaneo M, Frelinger AL, Newman PJ, Editors. Academic Press, Cambridge; 2019. pp.79-97 | ISBN: 9780128134566
Falet H. Anatomy of the platelet cytoskeleton. In: Platelets in Thrombotic and Non-Thrombotic Disorders: Pathophysiology, Pharmacology and Therapeutics: an Update. Gresele P, Kleiman NS, López JA, Page CP, Editors. Springer, New York; 2017. pp.139-156 | ISBN: 9783319474625
Hervé’s Bibliography on MyNCBI
https://www.ncbi.nlm.nih.gov/myncbi/1hI2on5sGApAz/bibliography/public/
X
https://twitter.com/hfalet
LinkedIn
https://www.linkedin.com/in/hervefalet/